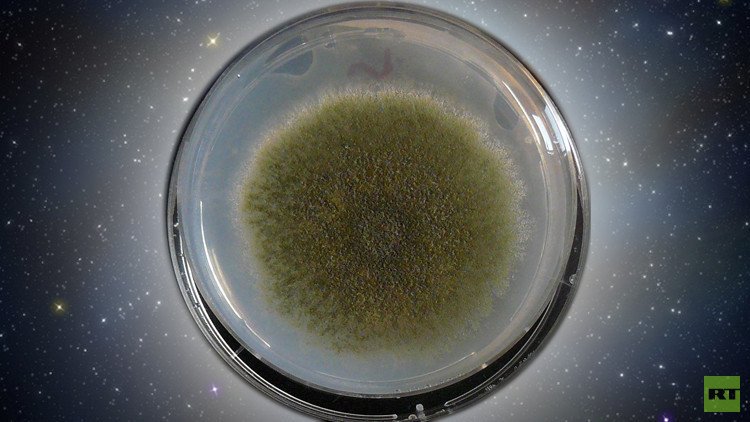
ناسا تنوي إرسال فُطر إلى الفضاء

Stories
-
![العملية العسكرية الروسية في أوكرانيا]()
العملية العسكرية الروسية في أوكرانيا
RT STORIES
ارتفاع حصيلة مصابي الاعتداء الإرهابي الأوكراني على حافلة في دونيتسك إلى 17 شخصا
![ارتفاع حصيلة مصابي الاعتداء الإرهابي الأوكراني على حافلة في دونيتسك إلى 17 شخصا]() #اسأل_أكثر #Question_More
#اسأل_أكثر #Question_MoreRT STORIES
لافروف: روسيا مستعدة لاتخاذ كافة التدابير لحماية دولة الاتحاد بين روسيا وبيلاروس
![لافروف: روسيا مستعدة لاتخاذ كافة التدابير لحماية دولة الاتحاد بين روسيا وبيلاروس]() #اسأل_أكثر #Question_More
#اسأل_أكثر #Question_MoreRT STORIES
أوشاكوف: إدارة ترامب سعت لحل نزاع أوكرانيا خلافا لإدارة بايدن
![أوشاكوف: إدارة ترامب سعت لحل نزاع أوكرانيا خلافا لإدارة بايدن]() #اسأل_أكثر #Question_More
#اسأل_أكثر #Question_MoreRT STORIES
القوات الأوكرانية تنسحب من أطراف قسطنطينوفكا تحت ضغط التقدم الروسي
![القوات الأوكرانية تنسحب من أطراف قسطنطينوفكا تحت ضغط التقدم الروسي]() #اسأل_أكثر #Question_More
#اسأل_أكثر #Question_MoreRT STORIES
مقتل خمسة أشخاص في هجوم صاروخي أوكراني على فورونيج
![مقتل خمسة أشخاص في هجوم صاروخي أوكراني على فورونيج]() #اسأل_أكثر #Question_More
#اسأل_أكثر #Question_More![العملية العسكرية الروسية في أوكرانيا]() العملية العسكرية الروسية في أوكرانيا
العملية العسكرية الروسية في أوكرانيا
-
![اتفاق أمريكي إيراني لوقف الحرب على جميع الجبهات]()
اتفاق أمريكي إيراني لوقف الحرب على جميع الجبهات
RT STORIES
طهران: محادثات سويسرا لم تتطرق لتفاصيل النووي وبدء المفاوضات مرهون بتنفيذ بنود المذكرة
![طهران: محادثات سويسرا لم تتطرق لتفاصيل النووي وبدء المفاوضات مرهون بتنفيذ بنود المذكرة]() #اسأل_أكثر #Question_More
#اسأل_أكثر #Question_MoreRT STORIES
لافروف: من الخطأ أن تتحد الدول العربية ضد إيران ولم نلمس مثل هذا التوجه
![لافروف: من الخطأ أن تتحد الدول العربية ضد إيران ولم نلمس مثل هذا التوجه]() #اسأل_أكثر #Question_More
#اسأل_أكثر #Question_MoreRT STORIES
بزشكيان: تقدم المفاوضات مرهون بالالتزام الأمريكي
![بزشكيان: تقدم المفاوضات مرهون بالالتزام الأمريكي]() #اسأل_أكثر #Question_More
#اسأل_أكثر #Question_MoreRT STORIES
طهران وواشنطن تشكلان 4 مجموعات عمل بعد مفاوضات سويسرا
![طهران وواشنطن تشكلان 4 مجموعات عمل بعد مفاوضات سويسرا]() #اسأل_أكثر #Question_More
#اسأل_أكثر #Question_MoreRT STORIES
ترامب حول رفض إسرائيل سحب القوات من لبنان: أعمل على حل المشاكل بما فيها تلك التي تتعلق بنتنياهو
![ترامب حول رفض إسرائيل سحب القوات من لبنان: أعمل على حل المشاكل بما فيها تلك التي تتعلق بنتنياهو]() #اسأل_أكثر #Question_More
#اسأل_أكثر #Question_MoreRT STORIES
ترامب عن إيران: طالما أنهم يحترموننا.. لا أريد استخدام كلمة "خوف" لأنها غير مناسبة
![ترامب عن إيران: طالما أنهم يحترموننا.. لا أريد استخدام كلمة "خوف" لأنها غير مناسبة]() #اسأل_أكثر #Question_More
#اسأل_أكثر #Question_More![اتفاق أمريكي إيراني لوقف الحرب على جميع الجبهات]() اتفاق أمريكي إيراني لوقف الحرب على جميع الجبهات
اتفاق أمريكي إيراني لوقف الحرب على جميع الجبهات
-
![مونديال 2026]()
مونديال 2026
RT STORIES
مبابي يكسر صمته بشأن رقم ميسي القياسي في كأس العالم
![مبابي يكسر صمته بشأن رقم ميسي القياسي في كأس العالم]() #اسأل_أكثر #Question_More
#اسأل_أكثر #Question_MoreRT STORIES
"النشامى" يودع كأس العالم 2026 رغم الأداء المشرف
!["النشامى" يودع كأس العالم 2026 رغم الأداء المشرف]() #اسأل_أكثر #Question_More
#اسأل_أكثر #Question_MoreRT STORIES
النرويج تكتب التاريخ وتحتفل بأسلوب "الفايكينغ" بعد إسقاط السنغال (فيديو)
![النرويج تكتب التاريخ وتحتفل بأسلوب "الفايكينغ" بعد إسقاط السنغال (فيديو)]() #اسأل_أكثر #Question_More
#اسأل_أكثر #Question_MoreRT STORIES
الجزائر تقلب الطاولة على الأردن وتفوز 2-1 في مونديال 2026
![الجزائر تقلب الطاولة على الأردن وتفوز 2-1 في مونديال 2026]() #اسأل_أكثر #Question_More
#اسأل_أكثر #Question_MoreRT STORIES
ما المنتخبات المتأهلة إلى دور الـ32 من كأس العالم 2026؟
![ما المنتخبات المتأهلة إلى دور الـ32 من كأس العالم 2026؟]() #اسأل_أكثر #Question_More
#اسأل_أكثر #Question_MoreRT STORIES
هالاند يكتب التاريخ.. أرقام قياسية جديدة في كأس العالم 2026
![هالاند يكتب التاريخ.. أرقام قياسية جديدة في كأس العالم 2026]() #اسأل_أكثر #Question_More
#اسأل_أكثر #Question_MoreRT STORIES
بعد ثنائية في شباك العراق.. مبابي يواصل التحطيم ويقترب من ميسي في صدارة تاريخية
![بعد ثنائية في شباك العراق.. مبابي يواصل التحطيم ويقترب من ميسي في صدارة تاريخية]() #اسأل_أكثر #Question_More
#اسأل_أكثر #Question_MoreRT STORIES
النرويج تحسم الإثارة أمام السنغال 3-2 في مباراة درامية
![النرويج تحسم الإثارة أمام السنغال 3-2 في مباراة درامية]() #اسأل_أكثر #Question_More
#اسأل_أكثر #Question_MoreRT STORIES
فرنسا تكتسح العراق بثلاثية وتحجز مقعدها في دور الـ32
![فرنسا تكتسح العراق بثلاثية وتحجز مقعدها في دور الـ32]() #اسأل_أكثر #Question_More
#اسأل_أكثر #Question_MoreRT STORIES
ميسي يهز شباك النمسا ويصبح الهداف التاريخي لبطولات كأس العالم
![ميسي يهز شباك النمسا ويصبح الهداف التاريخي لبطولات كأس العالم]() #اسأل_أكثر #Question_More
#اسأل_أكثر #Question_More![مونديال 2026]() مونديال 2026
مونديال 2026
-
فيديوهات
RT STORIES
غزة.. الطائرات الإسرائيلية تستهدف سيارة في حي الرمال
#اسأل_أكثر #Question_MoreRT STORIES
موسكو.. غرس 27 مليون شجرة بدعم من "حديقة الذاكرة"
#اسأل_أكثر #Question_Moreفيديوهات
-
لبنان.. فعالية بمناسبة "يوم الذكرى والحزن" في بيروت بعد مرور 85 عاما على بدء الحرب الوطنية العظمى
RT STORIES
لبنان.. فعالية بمناسبة "يوم الذكرى والحزن" في بيروت بعد مرور 85 عاما على بدء الحرب الوطنية العظمى
#اسأل_أكثر #Question_More -
![الأمن الروسي يحبط هجوما إرهابيا مزدوجا بتخطيط أوكراني]()
الأمن الروسي يحبط هجوما إرهابيا مزدوجا بتخطيط أوكراني
RT STORIES
الأمن الروسي يحبط هجوما إرهابيا مزدوجا بتخطيط أوكراني
![الأمن الروسي يحبط هجوما إرهابيا مزدوجا بتخطيط أوكراني]() #اسأل_أكثر #Question_More
#اسأل_أكثر #Question_More
ناسا تنوي إرسال فُطر إلى الفضاء
ستقوم ناسا بالتعاون مع جامعة كاليفورنيا الجنوبية بإرسال كمية صغيرة من الفُطر إلى المحطة الفضائية الدولية.
ويأمل الأطباء أن تبدأ جراثيم ذريّة الفطر في تشكيل أنواع جديدة من مضادات الحيوية وغيرها من جزيئات الأدوية في حالة انعدام الجاذبية الارضية.
وأعلن مدير التجربة الباحث كلاي وانغ من جامعة كاليفورنيا الجنوبية أن المستوى العالي للإشعاع والانعدام التام لجاذبية الأرض قد يحثان جراثيم ذريّة الفطر "Aspergillus nidulans " على إنتاج جزيئات يعجز الفطر عن إنتاجها في ظروف الأرض. وأضاف قائلا إن التحليل الوراثي يدل على أن هذا النوع من الفطر بوسعه إنتاج 40 جزيئا مفيداً. ومن ضمنها دواء يعالج مرض ترقق العظام (انخفاض كثافة العظام) الذي يعاني منه كثير من رواد الفضاء الذين يقضون وقتا طويلا على متن المحطة الفضائية الدولية.
يذكر أن التجربة يفترض أن تبدأ رسميا في الثامن من أبريل/ نيسان القادم عندما ستنطلق مركبة "سبايس – إكس" الأمريكية إلى المحطة الفضائية الدولية وستحمل على متنها دفعة من جراثيم ذريّة الفطر " Aspergillus nidulans ".
ويأمل العلماء أن يساعد تكاثر جراثيم الفطر في ظروف اللاوزن على إنتاج عدد من الجزيئات المفيدة التي ستحمي جسم الإنسان من مرض السرطان وتطور مرض الزهايمر.
يذكر أن جراثيم الفطر ستنمو في بيئة مغذية خاصة خلال 4 ايام. ثم سيقوم أفراد طاقم المحطة بتبريدها حتى 4 درجات حرارة مئوية فوق الصفر، ما سيجعل جراثيم الفطر " Aspergillus nidulans " تخلد إلى سبات عميق.
ويعول العلماء على أن تعود جراثيم الفطر إلى الأرض بحالة السبات هذه في مايو/ أيار القادم ليعالجها الدكتور وانغ وزملاؤه.
المصدر: نوفوستي




































































































































التعليقات